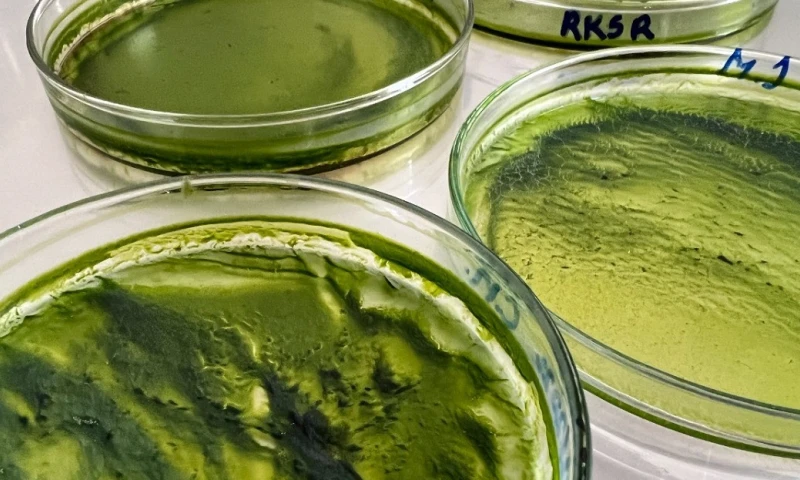
¿Cuál es el papel del CO2 en la nutrición de microalgas para el sector energético? / Foto: IIGE

Nacionales
¿Cuál es el papel del CO2 en la nutrición de microalgas para el sector energético?
En Ecuador, para el año 2020, las emisiones de CO2 gas alcanzaron las 33.740 ktonCO2 eq.
Las algas son organismos fotosintéticos que crecen en distintos hábitats y son capaces de convertir la energía solar y una fuente de carbono (en este caso CO2), en material orgánico o “biomasa”. Además, tienen la capacidad de sintetizar oxígeno y otros compuestos orgánicos como carbohidratos, grasas y proteínas. La investigación en microalgas es de gran importancia en la actualidad debido a los usos energéticos, principalmente para la obtención de biodiésel. Estos organismos pueden obtener CO2 para sus procesos biológicos por difusión desde la atmósfera o emisiones de gases industriales.
La fijación del gas CO2 es un proceso natural que lo desarrollan organismos fotosintéticos; el cual, permite captar el CO2 y la energía solar, transformando esta energía en compuestos con alto contenido de carbono. En el caso de las algas, se convierte en carbohidratos, lípidos, pigmentos y proteínas. Adicionalmente, se genera oxígeno como parte del proceso bioquímico.
El uso de CO2 como fuente para la masificación de micro algas permite tener una alternativa frente al incremento en las emisiones de gases de efecto invernadero y la disponibilidad de nutrientes (carbono); disminuyendo así, el gasto en medios de cultivo comerciales y, aprovechar los subproductos generados como parte del crecimiento, en este caso, con un enfoque energético.
Te invitamos a leer el artículo completo en el siguiente enlace: https://bit.ly/3ML3dzl
Síguenos en: